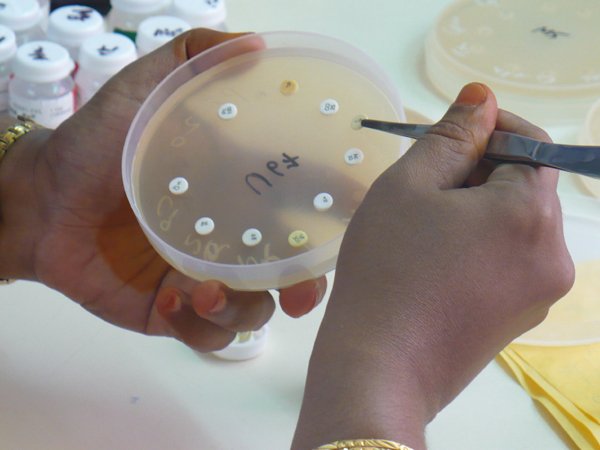

Microbiology
- Home
- Services
- Microbiology
Microbiology encompasses numerous sub-disciplines including virology, mycology, parasitology, and bacteriology.
Eukaryotic micro-organisms possess membrane-bound cell organelles and include fungi and protists, whereas prokaryotic organisms—all of which are microorganisms—are conventionally classified as lacking membrane-bound organelles and include eubacteria and archaebacteria. Microbiologists traditionally relied on culture, staining, and microscopy. However, less than 1% of the microorganisms present in common environments can be cultured in isolation using current means. Microbiologists often rely on extraction or detection of nucleic acid, either DNA or RNA sequences.
Viruses have been variably classified as organisms, as they have been considered either as very simple microorganisms or very complex molecules. Prions, never considered microorganisms, have been investigated by virologists, however, as the clinical effects traced to them were originally presumed due to chronic viral infections, and virologists took search—discovering "infectious proteins".
As an application of microbiology, medical microbiology is often introduced with medical principles of immunology as microbiology and immunology. Otherwise, microbiology, virology, and immunology as basic sciences have greatly exceeded the medical variants, applied sciences.
Pure Microbiology
- Bacteriology : the study of bacteria.
- Mycology : the study of fungi.
- Protozoology : the study of protozoa.
- Phycology/algology : the study of algae.
- Parasitology : the study of parasites.
- Immunology : the study of the immune system.
- Virology : the study of viruses.
- Nematology : the study of nematodes.
- Microbial cytology : the study of microscopic and submicroscopic details of microorganisms.
- Microbial physiology : the study of how the microbial cell functions biochemically. Includes the study of microbial growth, microbial metabolism and microbial cell structure.
- Microbial ecology : the relationship between microorganisms and their environment.
- Microbial genetics : the study of how genes are organized and regulated in microbes in relation to their cellular functions. Closely related to the field of molecular biology.
- Cellular microbiology : a discipline bridging microbiology and cell biology.
- Evolutionary microbiology : the study of the evolution of microbes. This field can be subdivided into:
- Microbial taxonomy : the naming and classification of microorganisms.
- Microbial systematic : the study of the diversity and genetic relationship of microorganisms.
- Generation microbiology : the study of those microorganisms that have the same characters as their parents.
- Systems microbiology : a discipline bridging systems biology and microbiology.
- Molecular microbiology : the study of the molecular principles of the physiological processes in microorganisms.